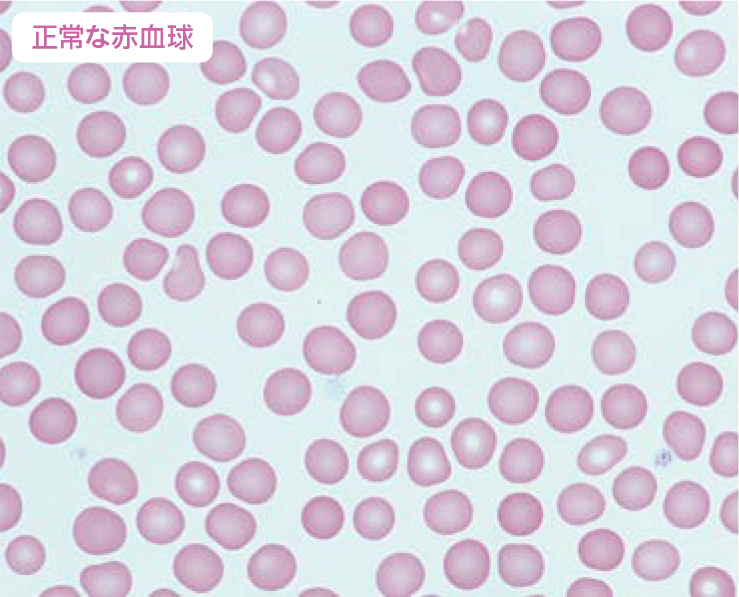
イメージ
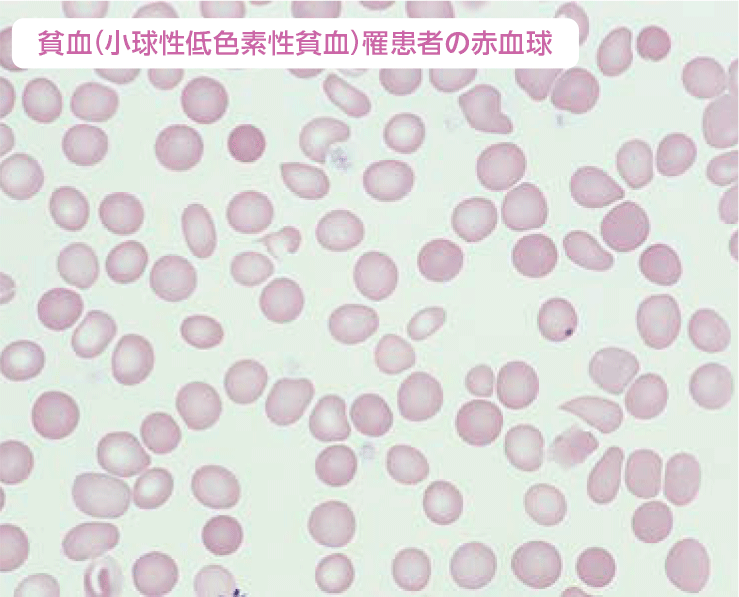
イメージ

「貧血」は、月経のある若い女性の10~20%が罹患しているとされるほど身近な病気。
血液の酸素を運ぶ能力が低下するため影響は全身に及びます。
貧血の種類と原因、治療についてイムス記念病院院長で血液内科のスペシャリスト金丸峯雄医師にうかがいました。
その不調、「貧血」かもしれません
貧血の正しい知識と治療法
医師紹介

イムス記念病院
院長
金丸 峯雄 医師
- 血液内科、内科
- 日本内科学会認定内科医
- 日本血液学会専門医・指導医
貧血の診断には血液検査が必須
ー顔色が悪い、下まぶたの裏側が白っぽい、立ちくらみやめまい、動悸が気になる……。
すると誰もが「貧血じゃないの?」と疑うくらい「貧血」はなじみ深い病気です。
しかし原因やメカニズムは知らない人が多いのでは。今回は血液内科の専門医である金丸院長に、正しい知識と治療法を教えていただきたいと思います。
金丸冒頭の症状は確かに「貧血」に当てはまります。ほかにも頭痛、疲れやすい、肌や髪がパサつく、爪が割れやすいなどを挙げることができます。しかしどの症状も、他の疾患が原因でも起こり得るものばかり。正解とはいえません。
貧血の医学的な定義は「血液中のヘモグロビン濃度が低下した状態」のことです。WHOの基準ではヘモグロビン濃度が成人男性で13g/dl以下、思春期及び成人女性は12g/dl以下を貧血とします。
血液検査をしない限り、医師でも診断はできないのです。
ーヘモグロビンとは何ですか?
金丸血液中の「赤血球」の主成分です。中心に鉄原子を持つタンパク質「ヘム」と、α鎖・β鎖からなる球状のタンパク質「グロビン」が結合した血色素です。
ヘモグロビンの役割は、体の隅々まで「酸素」を届けること。肺で鉄が酸素を受け取り酸化鉄になると(オキシヘモグロビン)鮮紅色に。体を巡って各組織に酸素を届け放出すると(デオキシヘモグロビン)暗紅色になります。動脈血と静脈血の色が異なるのは、この鉄の色の違いです。
ー鍵を握っているのは「鉄」なのですね。
金丸体内で鉄が不足すると、ヘモグロビンがきちんと合成できなくなります。すると全身が低酸素状態に陥り、生命維持活動が滞ってしまう。「貧血」とは慢性的な組織の低酸素状態と言い換えてもいいですね。頭痛や立ちくらみは脳の酸欠、息切れや動悸は肺や心臓の酸欠、倦怠感は筋肉の酸欠、肌荒れは皮膚の酸欠。
このような「鉄」不足が原因で起こる貧血を「鉄欠乏性貧血」と呼び、貧血全体のおよそ7割を占めています。
ー鉄を補えば、鉄欠乏性貧血は改善するのですか?
金丸多くの医療機関では鉄剤を処方します。おおむね1ヵ月でヘモグロビン濃度は改善に向かうでしょう。しかし、それで安心するのはまだ早く、鉄欠乏性貧血の中には「隠れ貧血」の患者さまがいらっしゃいます。治ったはずが、1〜2ヵ月もすると再発して、不調を訴えることになります。
ー隠れ貧血とは何ですか?
金丸鉄はヒトの体の中に3〜4g存在するとされ、その約65%は赤血球(ヘモグロビン)に含まれ、血液に乗って全身を巡っています。約25%は主に肝臓や脾臓(ひぞう)内の「フェリチン」というタンパク質と結びつき「貯蔵鉄」として蓄えられています。3〜5%はミオグロビンとして筋肉内に。残りは血漿内(血球をのぞいた血液成分)に「トランスフェリン」として存在します。
食事で摂った栄養素「鉄」の道程を見てみましょう。小腸から吸収⇒トランスフェリンに乗って肝臓・脾臓などに運ばれフェリチンとして一旦貯蔵⇒またトランスフェリンに乗り、赤血球・白血球・血小板を作る骨髄に送られる⇒ヘモグロビンとなって酸素を運搬。
隠れ貧血の原因は貯蔵鉄「フェリチン」の不足です。貯金がないのにお給料を使い果たしたら、すぐ生活が行き詰まるでしょう?
貧血も同じことです。
ーフェリチン不足は血液検査ではわからないのですか?
金丸わかります。貧血を疑った医師はフェリチン値(血清フェリチン値)とトランスフェリンの鉄結合能(TIBC)もオーダーするはずです。患者さまはヘモグロビン濃度に加え、この2つの数値を確認してください。
フェリチン不足が判明したら、半年〜1年ほど鉄剤を処方。飲み薬でなかなか改善しない場合は、静脈注射の鉄剤を追加し、慎重に経過を見守ることもあります。
ー鉄欠乏性貧血の原因は、やはり偏った食生活ですか?
金丸そうですね。特に閉経前の女性は1回の月経で20〜140mLの血液を失う負担があります。若い女性が過激なダイエットを行うのは注意が必要です。鉄は酸素運搬のほか、エネルギー代謝やDNA合成などの生理作用にも関わっているのでなおさらです。冷え性の一因にもなります。
また、月経量は個人差が大きく、自分が過多月経(150mL以上)かどうかの判断は難しいと思います。月経期間中ずっと頻繁なナプキン交換が必要で、日常生活に不自由を感じるレベルなら、一度婦人科を受診するとよいでしょう。子宮筋腫や子宮内膜症などの病気が隠れていると、月経量が増えるので注意が必要です。
ー治療と併行して、心がけたい食生活の注意点をお願いします。
金丸厚生労働省によると、月経のある成人女性の1日当たりの推奨鉄摂取量は10・5〜11mg。成人男性は7・5mg、閉経後の女性は6・5mgです。
動物性のヘム鉄が豊富なレバーがよいといわれますが、好き嫌いがあります。ウシ・ブタなど哺乳類の赤身肉がおすすめです。ヒトと同じ構造のヘモグロビンを多く含んでいます。週に3回は積極的に食べてください。他にカツオの血合いやマグロの赤身もおすすめです。
ホウレン草やヒジキが含む鉄は植物性の非ヘム鉄で、残念ながらヘム鉄の5分の1程度しか吸収されないといわれます。
他にビタミンB12や葉酸が不足すると正常な血球が作れず「巨赤芽球性貧血」を引き起こします。また、亜鉛や銅の極端な不足でも貧血を招きますので、バランスの良い食事を心がけましょう。

赤血球のイメージ図。直径7~8μmで、中央が窪んだ円盤型。骨髄で作られ寿命は約120日。脾臓で分解され、「鉄」の大半は再吸収・再利用される。二酸化炭素回収の役目も担っている
鉄欠乏性貧血のほかにもさまざまな貧血が
ー鉄欠乏性貧血のほかには、どのような貧血がありますか?
金丸タイプ別に貧血の原因を説明しましょう。
①赤血球を作る能力が低下して起こるタイプ
・腎臓疾患の患者さまに見られる赤血球生成を助けるホルモン・エリスロポエチンが、腎臓から十分に分泌されず発症する「腎性貧血」。
・「甲状腺機能低下症」に罹患すると全身の代謝が落ちるため、赤血球生成も滞って貧血が起きます。
・骨髄の造血能力が低下する疾患「再生不良性貧血」、正常な血液を作れない「骨髄異形成症候群」、「白血病など血液のがん」などに伴う貧血。
② 赤血球が失われたり、壊れたりするタイプ
・内臓にできた潰瘍や悪性腫瘍から出血があり失血で貧血を発症します。痔疾も原因となります。
・心臓弁膜症で人工の機械弁を入れていると、その影響で赤血球の一部が壊れ貧血になります。
・自分自身の赤血球を攻撃する抗体が作られる疾患「自己免疫性溶血性貧血」。
③ 慢性的な炎症性疾患を原因とするタイプ
・代表例は「関節リウマチ」。日本には約80万人の罹患者がいます。他には慢性的に続く感染症の方。これは貯蔵鉄の活用を制御するホルモン・ヘプシジンが炎症で亢進し、活用を妨げるため起きます。この場合血清鉄は低下しますが、血清フェリチン値は高いため診断の参考になります。
ーいろいろあるのですね。
金丸一般的な健康診断・人間ドックで行う血液検査や尿検査の結果を専門医が拝見すれば、疑わしい疾患を推察し精密検査につなげることができます。定期健診はさまざまな病気の早期発見・早期治療の要です。
特に臨床現場では、貧血の背後にある悪性腫瘍を見逃すわけにはいきません。私は胃と大腸の内視鏡検査を含むがん検診を、積極的におすすめしています。
ー貧血を甘くみてはいけないことが、よくわかりました。素人判断で安易に「鉄」のサプリメントに頼っていてはダメですね。
金丸はい。サプリメントの鉄含有量は、医師が処方する鉄剤の10分の1以下のものもあります。必ず医療機関を受診し、正しい診断の下で治療を受けてください。
ーありがとうございました。
赤血球の顕微鏡写真

貧血罹患者の赤血球は、健常者の赤血球と比べ、小ぶりで形に歪みがあり不完全なものが混ざる。
鉄不足でヘモグロビンがきちんと合成できず数も少なめ《 写真提供:株式会社アイル》


イムス記念病院

